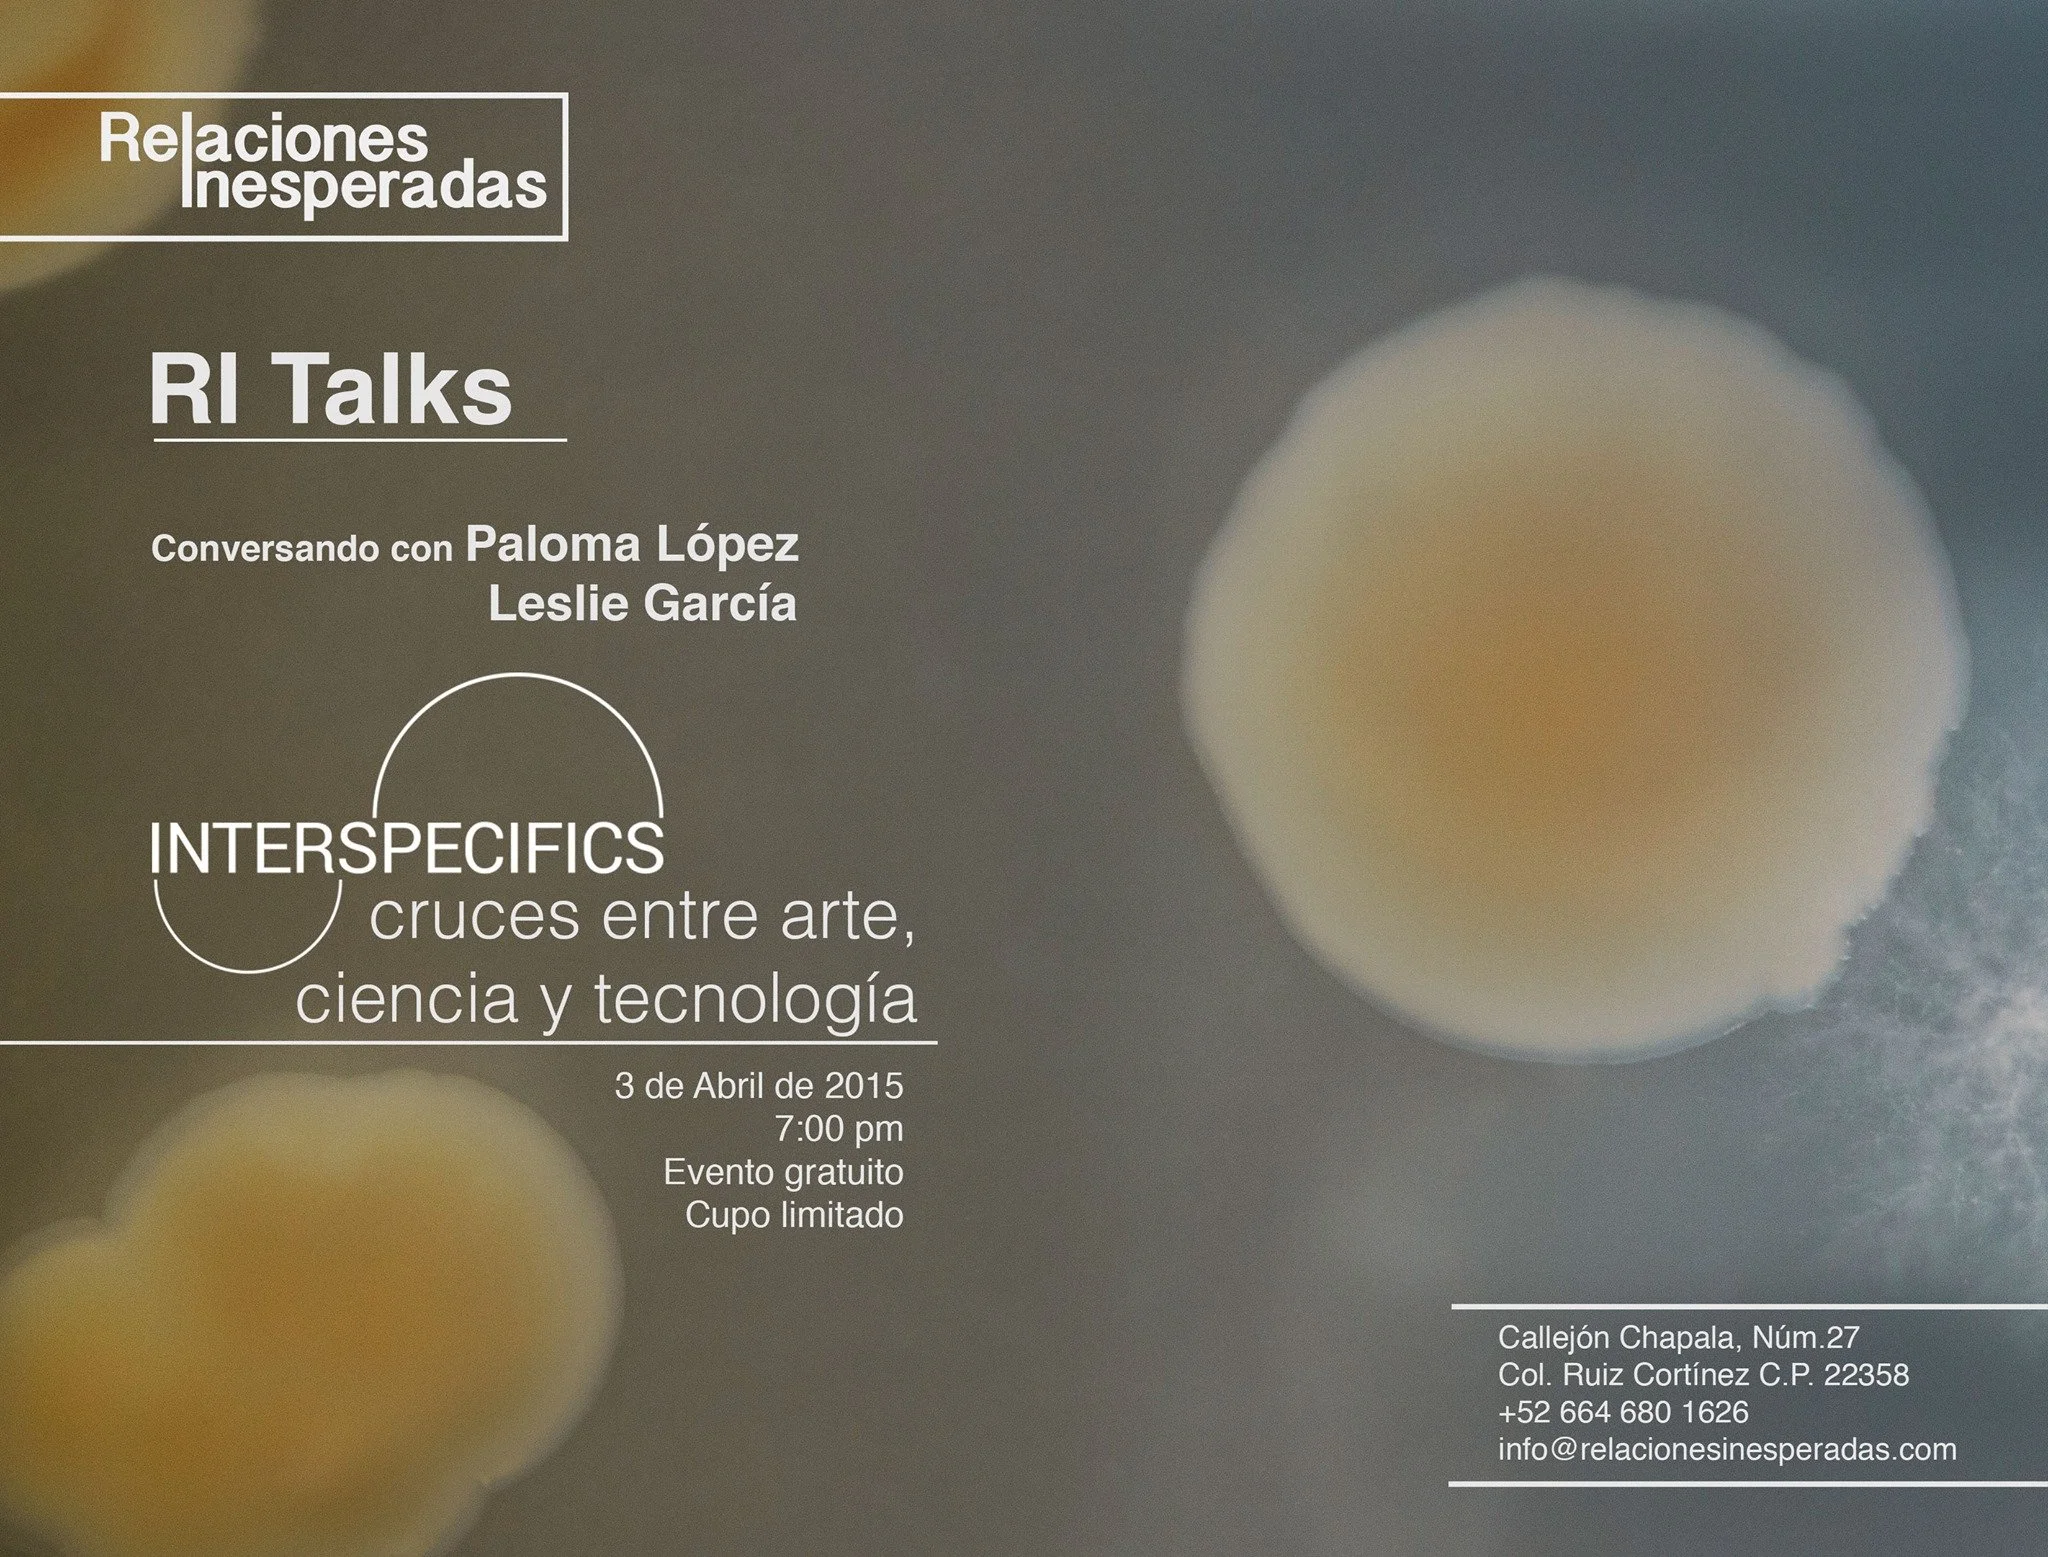

Desde 2012 Relaciones Inesperadas opera como un espacio independiente y autogestionado, dedicado a la reflexión y al desarrollo de prácticas artísticas basadas en el proceso y el trabajo a largo plazo en estrecha relación con diversas comunidades, mediante enfoques multidisciplinarios e investigación artística. A través de programas educativos, residencias y exhibiciones, busca propiciar la colaboración y la producción de conocimiento en este campo.

Programa de Producción de Arte Contemporáneo 01

Programa de Creación Cinematográfica
INTERSPECIFICS: Cruces entre arte, ciencia y tecnología - RI Talk

Pélicula - Chechè lavi (buscando una vida)

Cristian Franco

REBORDE - Exhibición

Cultura ciudadana: procesos estéticos y política pública - RI Talk

Programa Permanente de Producción
